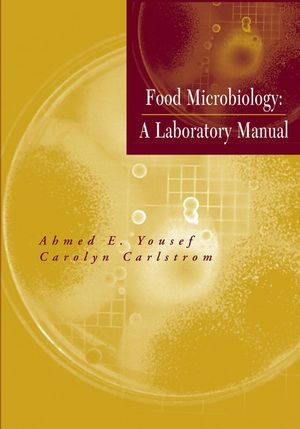
Food Microbiology - Ahmed E. Yousef, Carolyn Carlstrom

Food Microbiology
Wiley-Interscience (Verlag)
978-0-471-39105-0 (ISBN)
- Titel erscheint in neuer Auflage
- Artikel merken
Yousef and Carlstrom’s Food Microbiology: A Laboratory Manual serves as a general laboratory manual for undergraduate and graduate students in food microbiology, as well as a training manual in analytical food microbiology. Focusing on basic skill-building throughout, the Manual provides a review of basic microbiological techniques–media preparation, aseptic techniques, dilution, plating, etc.–followed by analytical methods and advanced tests for food-bourne pathogens. The Manual includes a total of fourteen complete experiments. The first of the Manual’s four sections reviews basic microbiology techniques; the second contains exercises to evaluate the microbiota of various foods and enumerate indicator microorganisms. Both of the first two sections emphasize conventional cultural techniques. The third section focuses on procedures for detecting pathogens in food, offering students the opportunity to practice cultural, biochemical, immunoassay, and genetic methods. The final section discusses beneficial microorganisms and their role in food fermentations, concentrating on lactic acid bacteria and their bacteriocins. This comprehensive text also:
- Focuses on detection and analysis of food-bourne pathogenic microorganisms like Escherichia coli 0157:H7, Listeria monocytogenes, and Salmonella
- Includes color photographs on a companion Web site in order to show students what their own petri plates or microscope slides should look like: http://class.fst.ohio-state.edu/fst636/fst636.htm
- Explains techniques in an accessible manner, using flow charts and drawings
- Employs a "building block" approach throughout, with each new chapter building upon skills from the previous chapter
AHMED E. YOUSEF, PhD, is a professor of food microbiology in the Department of Food Science and Technology and the Department of Microbiology at The Ohio State University in Columbus, Ohio. He has served on the editorial boards of the Journal of Food Protection and the Journal of Food Science. CAROLYN CARLSTROM is a Graduate Teaching Associate in the Department of Microbiology at The Ohio State University, as well as a PhD candidate with a specialization in environmental microbiology.
PREFACE. PART I. BASICS OF FOOD MICROBIOLOGY LABORATORY.
1. BASIC MICROBIOLOGICAL TECHNIQUES.
PART II. FOOD MICROBIOTA.
2. TOTAL PLATE COUNT.
3. YEASTS AND MOLDS.
4. COLIFORM COUNT IN FOOD.
5. MESOPHILIC AEROBIC AND ANAEROBIC SPORES.
6. MICROBIOTA OF FOOD PROCESSING ENVIRONMENT.
PART III. FOOD-TRANSMITTED PATHOGENS.
7. Staphylococcus aureus.
8. Listeria monocytogenes.
9. Salmonella.
10. Escherichia coli O157:H7.
PART IV. FOOD FERMENTATION.
11. LACTIC ACID FERMENTATION AND BACTERIOCIN PRODUCTION.
APPENDIX A: LABORATORY EXERCISE REPORT.
APPENDIX B: MICROBIAL GROWTH KINETICS.
APPENDIX C: MICROBIOLOGICAL MEDIA.
INDEX.
| Erscheint lt. Verlag | 20.5.2003 |
|---|---|
| Sprache | englisch |
| Maße | 178 x 255 mm |
| Gewicht | 522 g |
| Themenwelt | Naturwissenschaften ► Biologie ► Mikrobiologie / Immunologie |
| Technik ► Lebensmitteltechnologie | |
| Weitere Fachgebiete ► Land- / Forstwirtschaft / Fischerei | |
| ISBN-10 | 0-471-39105-0 / 0471391050 |
| ISBN-13 | 978-0-471-39105-0 / 9780471391050 |
| Zustand | Neuware |
| Informationen gemäß Produktsicherheitsverordnung (GPSR) | |
| Haben Sie eine Frage zum Produkt? |
aus dem Bereich



